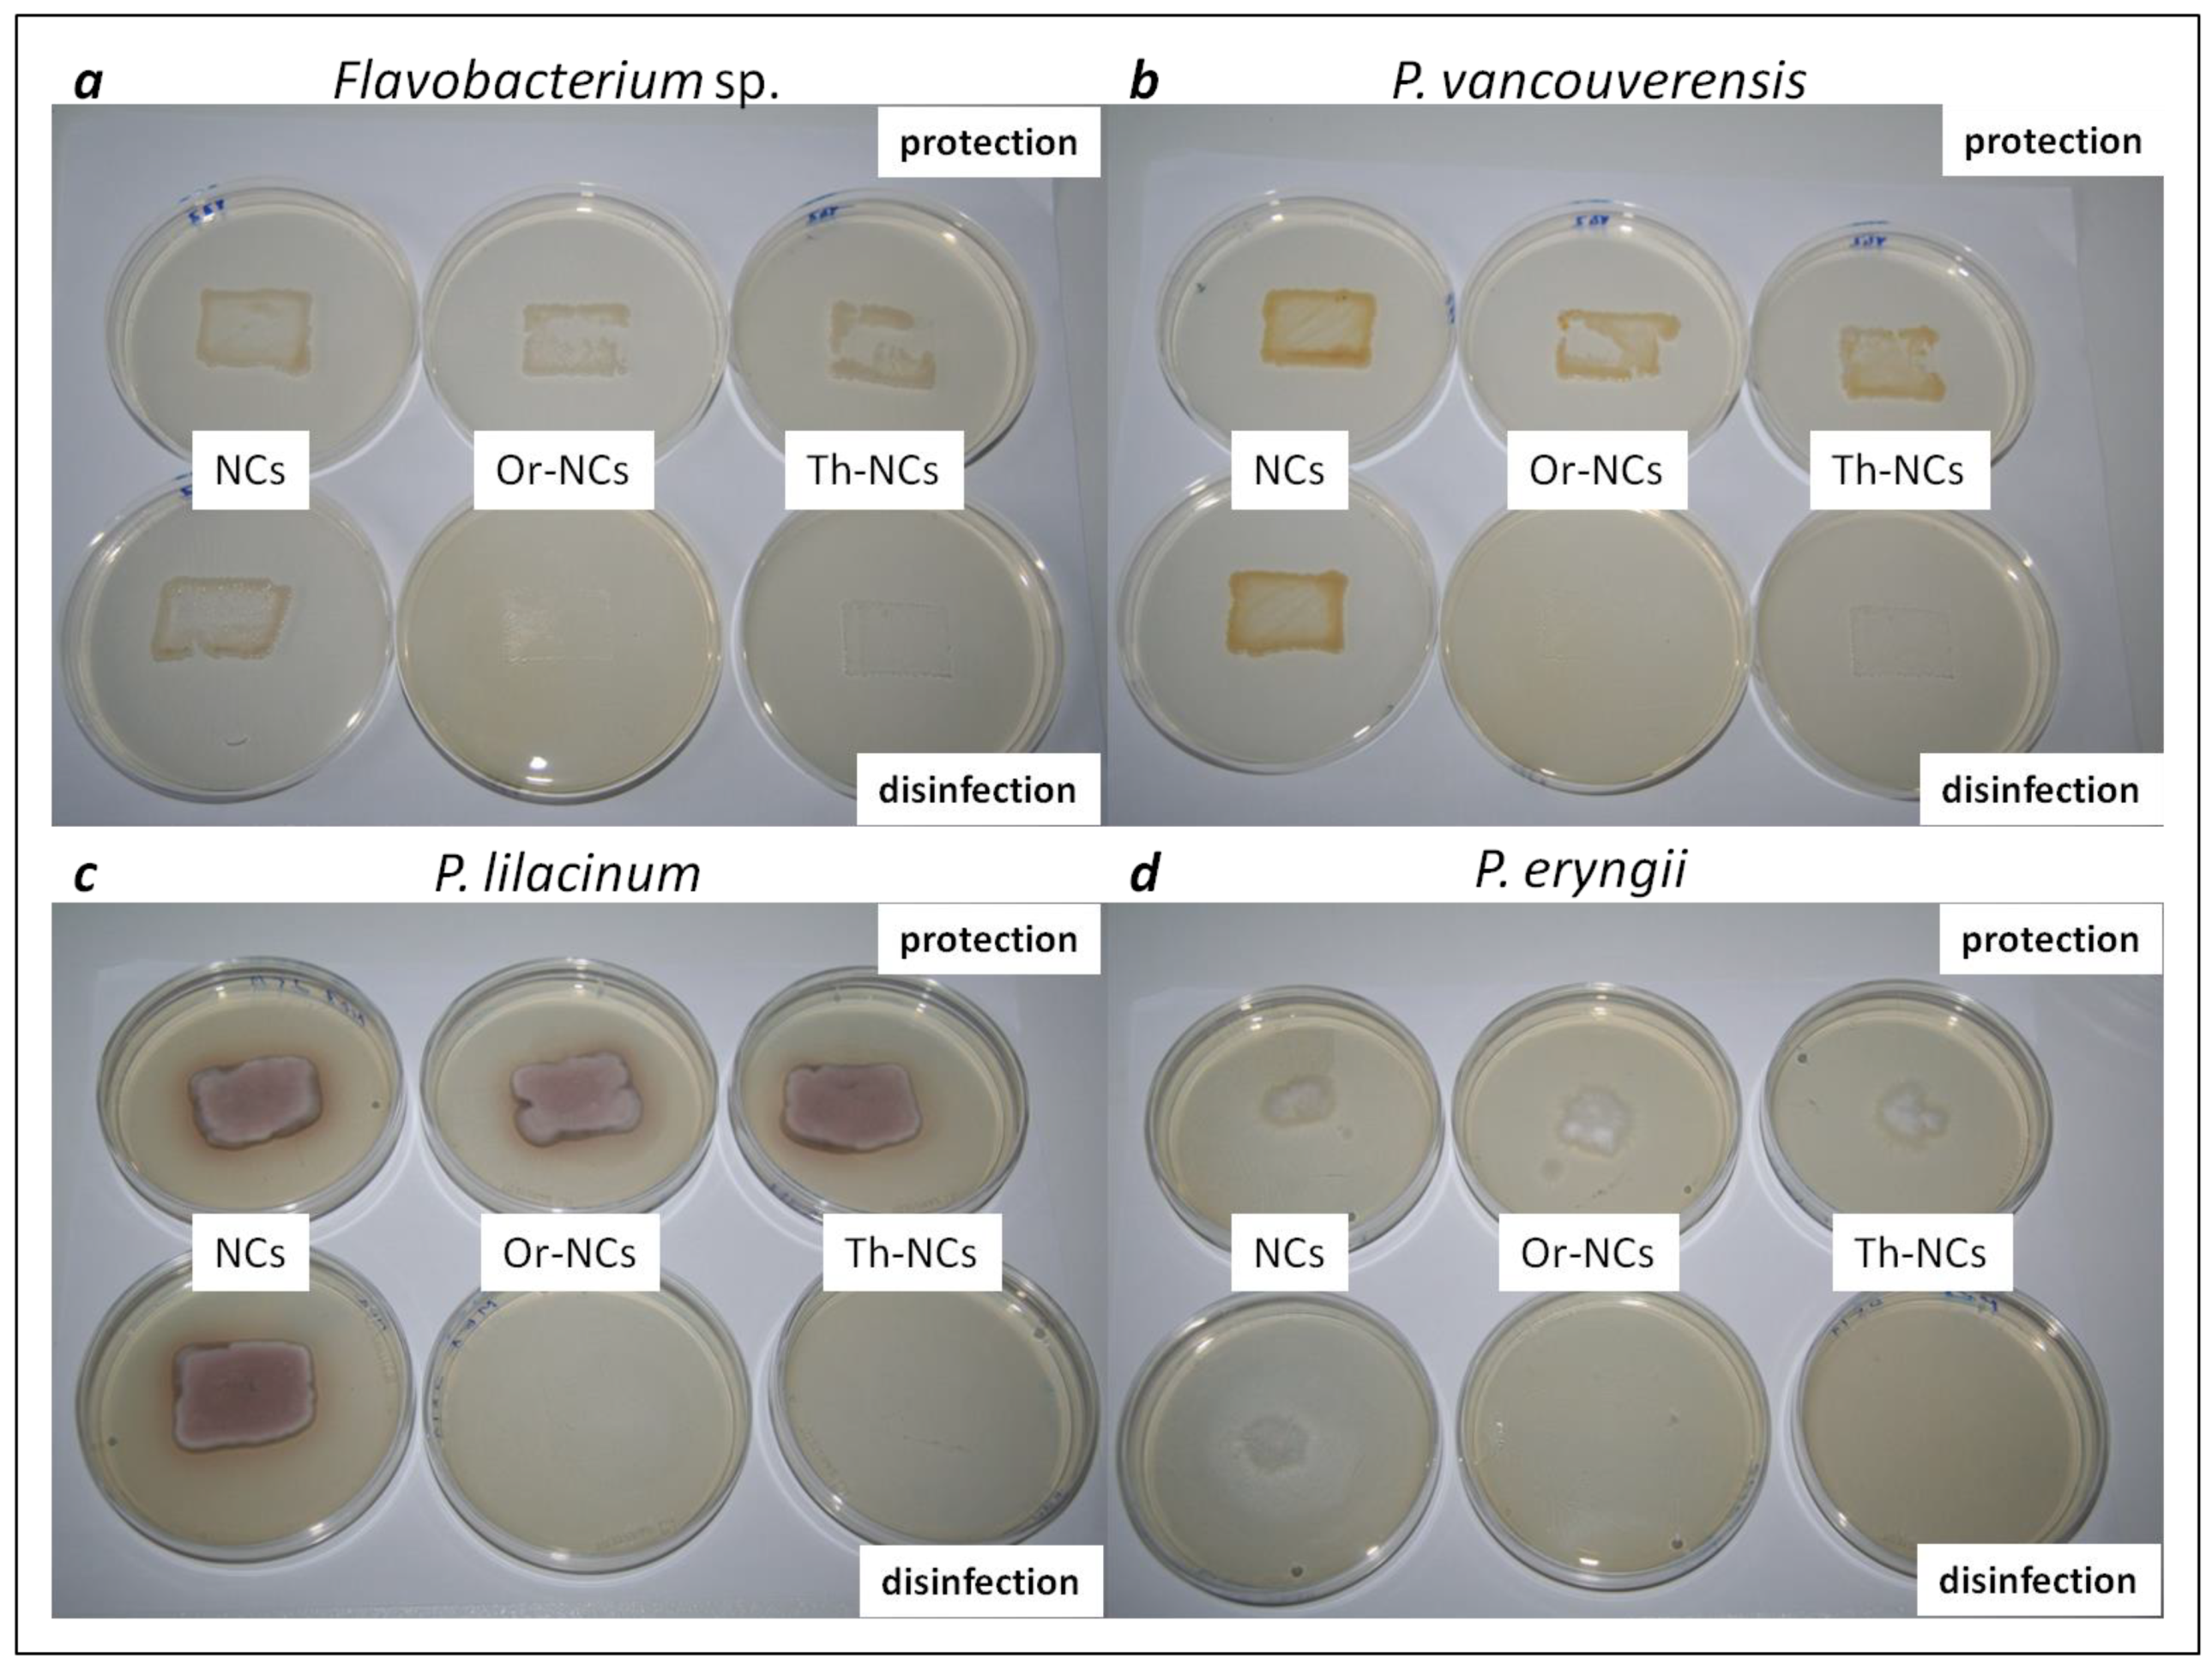
Molecules 28 01018 g002 Molecules 28 01018 g002

Protection and Disinfection Activities of Oregano and Thyme Essential Oils Encapsulated in Poly(ε-caprolactone) Nanocapsules
Abstract
1. Introduction
2. Results and Discussion
2.1. Biofilm Inhibitory Activity
2.2. Determination of Microbial Activity on Wood and Sandstone Surfaces
2.3. Measurement of the Optical Properties of Materials before and after the Application of NCs and EO-NCs in the Presence or Absence of Microbial Cultures
3. Materials and Methods
3.1. Nanocapsules and Essential Oils
3.2. Microbial Strains and Growth Conditions
3.3. Minimum Inhibitory Concentration (MIC)
3.4. Microtiter Biofilm Assay
3.5. Antimicrobial Activity on the Sandstone and Whitewood Samples
3.6. Detection of Microbial Activity on the Substrates’ Surface
3.7. Measurement of Optical Properties
4. Conclusions
Author Contributions
Funding
Institutional Review Board Statement
Informed Consent Statement
Data Availability Statement
Conflicts of Interest
Sample Availability
References
- Sanchez-Silva, M.; Rosowsky, D.V. Biodeterioration of Construction Materials: State of the Art and Future Challenges. J. Mater. Civ. Eng. 2008, 20, 352–365. [Google Scholar] [CrossRef]
- Romano, I.; Granata, G.; Poli, A.; Finore, I.; Napoli, E.; Geraci, C. Inhibition of Bacterial Growth on Marble Stone of 18th Century by Treatment of Nanoencapsulated Essential Oils. Int. Biodeterior. Biodegrad. 2020, 148, 104909. [Google Scholar] [CrossRef]
- Rivera, L.E.C.; Ramos, A.P.; Sánchez, J.I.C.; Drago Serrano, M.E. Origin and Control Strategies of Biofilms in the Cultural Heritage. In Antimicrobials, Antibiotic Resistance, Antibiofilm Strategies and Activity Methods; Kırmusaoğlu, S., Ed.; IntechOpen: London, UK, 2018; pp. 1–24. [Google Scholar] [CrossRef]
- Ahmed, T.; Usman, M.; Scholz, M. Biodeterioration of buildings and public health implications caused by indoor air pollution. Indoor Built Environ. 2017, 27, 752–765. [Google Scholar] [CrossRef]
- Lepage, R.; Glass, S.V.; Knowles, W.; Mukhopadhyaya, P. Biodeterioration Models for Building Materials: Critical Review. J. Arch. Eng. 2019, 25, 040190212019. [Google Scholar] [CrossRef]
- Bennett, J.W.; Klich, M. Mycotoxins. Clin. Microbiol. Rev. 2003, 16, 497–516. [Google Scholar] [CrossRef] [PubMed]
- Meng, H.; Zhang, X.; Katayama, Y.; Ge, Q.; Gu, J.-D. Microbial diversity and composition of the Preah Vihear temple in Cambodia by high-throughput sequencing based on genomic DNA and RNA. Int. Biodeterior. Biodegradation 2020, 149, 104936. [Google Scholar] [CrossRef]
- Corbeddu, M.; Ferreli, C.; Cappai, R.; Ferraguti, P.; Atzori, L.; Pilloni, L.; Rongioletti, F. Fatal hyalohyphomycosis with cutaneous involvement caused by Purpureocillium lilacinum in an immunocompromised patient with bullous pemphigoid. Acta Bio-Med. Atenei Parm. 2021, 92, e2021139. [Google Scholar] [CrossRef]
- Sharma, A.; Sharma, S.; Mittal, A.; Naik, S.N. Evidence for the involvement of nematocidal toxins of Purpureocillium lilacinum 6029 cultured on Karanja deoiled cake liquid medium. World J. Microbiol. Biotechnol. 2016, 32, 1–5. [Google Scholar] [CrossRef]
- Kapustová, M.; Granata, G.; Napoli, E.; Puškárová, A.; Bučková, M.; Pangallo, D.; Geraci, C. Nanoencapsulated Essential Oils with Enhanced Antifungal Activity for Potential Application on Agri-Food, Material and Environmental Fields. Antibiotics 2021, 10, 31. [Google Scholar] [CrossRef]
- Sufiate, B.L.; Soares, F.E.D.F.; Moreira, S.S.; Gouveia, A.D.S.; Monteiro, T.S.A.; de Freitas, L.G.; de Queiroz, J.H. Nematicidal action of Pleurotus eryngii metabolites. Biocatal. Agric. Biotechnol. 2017, 12, 216–219. [Google Scholar] [CrossRef]
- Benkovičová, M.; Kisová, Z.; Bučková, M.; Majková, E.; Šiffalovič, P.; Pangallo, D. The Antifungal Properties of Super-Hydrophobic Nanoparticles and Essential Oils on Different Material Surfaces. Coatings 2019, 9, 176. [Google Scholar] [CrossRef]
- Lavin, P.; de Saravia, S.G.; Guiamet, P. Scopulariopsis sp. and Fusarium sp. in the Documentary Heritage: Evaluation of Their Biodeterioration Ability and Antifungal Effect of Two Essential Oils. Microb. Ecol. 2015, 71, 628–633. [Google Scholar] [CrossRef] [PubMed]
- Guimarães, A.C.; Meireles, L.M.; Lemos, M.F.; Guimarães, M.C.C.; Endringer, D.C.; Fronza, M.; Scherer, R. Antibacterial Activity of Terpenes and Terpenoids Present in Essential Oils. Molecules 2019, 24, 2471. [Google Scholar] [CrossRef] [PubMed]
- Fokou, J.B.H.; Dongmo, P.M.J.; Boyom, F.F. Essential Oil’s Chemical Composition and Pharmacological Properties. In Essential Oils—Oils of Nature; El-Shemy, H.A., Ed.; IntechOpen: London, UK, 2020. [Google Scholar] [CrossRef]
- Gallucci, M.N.; Oliva, M.; Casero, C.; Dambolena, J.; Luna, A.; Zygadlo, J.; Demo, M. Antimicrobial combined action of terpenes against the food-borne microorganisms Escherichia coli, Staphylococcus aureus and Bacillus cereus. Flavour Fragr. J. 2009, 24, 348–354. [Google Scholar] [CrossRef]
- Gupta, S.; Variyar, P.S. 15—Nanoencapsulation of Essential Oils for Sustained Release: Application as Therapeutics and Antimicrobials. In Nanotechnology in the Agri-Food Industry, Encapsulations; Grumezescu, A.M., Ed.; Academic Press: Cambridge, MA, USA, 2016; pp. 641–672. [Google Scholar] [CrossRef]
- Lammari, N.; Louaer, O.; Meniai, A.H.; Elaissari, A. Encapsulation of essential oils via nanoprecipitation process: Overview, progress, challenges and prospects. Pharmaceutics 2020, 12, 431. [Google Scholar] [CrossRef] [PubMed]
- Herculano, E.D.; de Paula, H.C.; de Figueiredo, E.A.; Dias, F.G.; Pereira, V.D.A. Physicochemical and antimicrobial properties of nanoencapsulated Eucalyptus staigeriana essential oil. Lwt 2015, 61, 484–491. [Google Scholar] [CrossRef]
- Froiio, F.; Ginot, L.; Paolino, D.; Lebaz, N.; Bentaher, A.; Fessi, F.; Elaissari, A. Essential oils-loaded polymer particles: Preparation, characterization and antimicrobial property. Polymers 2019, 11, 1017. [Google Scholar] [CrossRef]
- Pattabhiramaiah, M.; Rajarathinam, B.; Shanthala, M. Nanoparticles and Their Application in Folklore Medicine as Promising Biotherapeutics; Prasad, D., Jeyabalan, T., Ram, S., Eds.; Functional Bionanomaterials, Springer International Publishing: Berlin/Heidelberg, Germany, 2020; pp. 73–110. [Google Scholar]
- Lammari, N.; Demautis, T.; Louaer, O.; Meniai, A.H.; Casabianca, H.; Bensouici, C.; Devouassoux, G.; Fessi, H.; Bentaher, A.; Elaissari, A. Nanocapsules containing Saussurea lappa essential oil: Formulation, characterization, antidiabetic, anti-cholinesterase and anti-inflammatory potentials. Int. J. Pharm. 2020, 593, 120138. [Google Scholar] [CrossRef]
- Weisany, W.; Yousefi, S.; Tahir, N.A.-R.; Zadeh, N.G.; McClements, D.J.; Adhikari, B.; Ghasemlou, M. Targeted delivery and controlled released of essential oils using nanoencapsulation: A review. Adv. Colloid Interface Sci. 2022, 303, 102655. [Google Scholar] [CrossRef]
- Choi, M.-J.; Soottitantawat, A.; Nuchuchua, O.; Min, S.-G.; Ruktanonchai, U. Physical and light oxidative properties of eugenol encapsulated by molecular inclusion and emulsion–diffusion method. Food Res. Int. 2009, 42, 148–156. [Google Scholar] [CrossRef]
- Lv, Y.; Yang, F.; Li, X.; Zhang, X.; Abbas, S. Formation of heat-resistant nanocapsules of jasmine essential oil via gelatin/gum arabic based complex coacervation. Food Hydrocoll. 2013, 35, 305–314. [Google Scholar] [CrossRef]
- Jummes, B.; Sganzerla, W.G.; da Rosa, C.G.; Noronha, C.M.; Nunes, M.R.; Bertoldi, F.C.; Barreto, P.L.M. Antioxidant and antimicrobial poly-ε-caprolactone nanoparticles loaded with Cymbopogon martinii essential oil. Biocatal. Agric. Biotechnol. 2020, 23, 101499. [Google Scholar] [CrossRef]
- Ephrem, E.; Greige-Gerges, H.; Fessi, H.; Charcosset, C. Optimisation of rosemary oil encapsulation in polycaprolactone and scale-up of the process. J. Microencapsul. 2014, 31, 746–753. [Google Scholar] [CrossRef] [PubMed]
- Granata, G.; Stracquadanio, S.; Leonardi, M.; Napoli, E.; Consoli, G.M.L.; Cafiso, V.; Stefani, S.; Geraci, C. Essential oils encapsulated in polymer-based nanocapsules as potential candidates for application in food preservation. Food Chem. 2018, 269, 286–292. [Google Scholar] [CrossRef]
- Budri, P.; Silva, N.C.C.; Bonsaglia, E.C.; Fernandes, A.A.H.; Araújo, J.; Doyama, J.; Gonçalves, J.L.; Santos, M.V.; Fitzgerald-Hughes, D.; Rall, V.L.M. Effect of essential oils of Syzygium aromaticum and Cinnamomum zeylanicum and their major components on biofilm production in Staphylococcus aureus strains isolated from milk of cows with mastitis. J. Dairy Sci. 2015, 98, 5899–5904. [Google Scholar] [CrossRef] [PubMed]
- Mohamed, A.E.-A.A.R.; Rashed, A.-O.M.; Mahmoud, M.A.; Shehata, S.M.; Abdelazim, N.S. Chitosan Nanoparticles as a Carrier for Mentha longifolia Extract:Synthesis, Characterization and Antifungal Activity. Curr. Sci. 2018, 114, 2116–2122. [Google Scholar] [CrossRef]
- Izadi, M.; Jorf, S.A.M.; Nikkhah, M.; Moradi, S. Antifungal activity of hydrocolloid nano encapsulated Carum copticum essential oil and Peganum harmala extract on the pathogenic fungi Alternaria alternata. Physiol. Mol. Plant Pathol. 2021, 116, 101714. [Google Scholar] [CrossRef]
- Kapustová, M.; Puškárová, A.; Bučková, M.; Granata, G.; Napoli, E.; Annušová, A.; Mesárošová, M.; Kozics, K.; Pangallo, D.; Geraci, C. Biofilm Inhibition by Biocompatible Poly(ε-Caprolactone) Nanocapsules Loaded with Essential Oils and Their Cyto/Genotoxicity to Human Keratinocyte Cell Line. Int. J. Pharm. 2021, 606, 120846. [Google Scholar] [CrossRef]
- Cai, L.; Lim, H.; Nicholas, D.D.; Kim, Y. Bio-based Preservative using Methyl-β-cyclodextrin-Essential Oil Complexes for Wood Protection. Int. J. Biol. Macromol. 2020, 147, 420–427. [Google Scholar] [CrossRef]
- Tari, S.M.M.; Tarmian, A.; Azadfallah, M. Improving fungal decay resistance of solvent and waterborne polyurethane-coated wood by free and microencapsulated thyme essential oil. J. Coat. Technol. Res. 2022, 19, 959–966. [Google Scholar] [CrossRef]
- Ranaldi, R.; Rugnini, L.; Gabriele, F.; Spreti, N.; Casieri, C.; Di Marco, G.; Gismondi, A.; Bruno, L. Plant essential oils suspended into hydrogel: Development of an easy-to-use protocol for the restoration of stone cultural heritage. Int. Biodeterior. Biodegradation 2022, 172, 105436. [Google Scholar] [CrossRef]
- Pánek, M.; Reinprecht, L.; Hulla, M. Ten essential oils for beech wood protection-efficacy against wood-destroying fungi and moulds, and effect on wood discoloration. BioResources 2014, 9, 5588–5603. [Google Scholar] [CrossRef]
- Adil, M.; Singh, K.; Verma, P.K.; Khan, A.U. Eugenol-induced suppression of biofilm-forming genes in Streptococcus mutans: An approach to inhibit biofilms. J. Glob. Antimicrob. Resist. 2014, 2, 286–292. [Google Scholar] [CrossRef] [PubMed]
- Rajkowska, K.; Nowicka-Krawczyk, P.; Kunicka-Styczyńska, A. Effect of clove and thyme essential oils on Candida biofilm formation and the oil distribution in yeast cells. Molecules 2019, 24, 1954. [Google Scholar] [CrossRef] [PubMed]
- Palla, F.; Bruno, M.; Mercurio, F.; Tantillo, A.; Rotolo, V. Essential oils as natural biocides in conservation of cultural heritage. Molecules 2020, 25, 730. [Google Scholar] [CrossRef]
- Ilieș, D.C.; Hodor, N.; Indrie, L.; Dejeu, P.; Ilieș, A.; Albu, A.; Caciora, T.; Ilieș, M.; Barbu-Tudoran, L.; Grama, V. Investigations of the surface of heritage objects and green bioremediation: Case study of artefacts from Maramureş, Romania. Appl. Sci. 2021, 11, 6643. [Google Scholar] [CrossRef]
- Macedo-Arantes, S.; Piçarra, A.; Caldeira, A.T.; Candeias, A.E.; Martins, M.R. Essential oils of Portuguese flavouring plants: Potential as green biocides in cultural heritage. Eur. Phys. J. Plus 2021, 136, 1106. [Google Scholar] [CrossRef]
- Kačániová, M.; Galovičová, L.; Borotová, P.; Valková, V.; Ďúranová, H.; Kowalczewski, P.; Ahl, H.A.H.S.-A.; Hikal, W.M.; Vukic, M.; Savitskaya, T.; et al. Chemical Composition, In Vitro and In Situ Antimicrobial and Antibiofilm Activities of Syzygium aromaticum (Clove) Essential Oil. Plants 2021, 10, 2185. [Google Scholar] [CrossRef]
- Poaty, B.; Lahlah, J.; Porqueres, F.; Bouafif, H. Composition, antimicrobial and antioxidant activities of seven essential oils from the North American boreal forest. World J. Microbiol. Biotechnol. 2015, 31, 907–919. [Google Scholar] [CrossRef]
- Harriott, M.M.; Noverr, M.C. Candida albicans and Staphylococcus aureus Form Polymicrobial Biofilms: Effects on Antimicrobial Resistance. Antimicrob. Agents Chemother. 2009, 53, 3914–3922. [Google Scholar] [CrossRef]
- Mowat, E.; Butcher, J.; Lang, S.; Williams, C.; Ramage, G. Development of a simple model for studying the effects of antifungal agents on multicellular communities of Aspergillus fumigatus. J. Med. Microbiol. 2007, 56, 1205–1212. [Google Scholar] [CrossRef] [PubMed]

| Strain | MIC (mg/mL) | Sub-MIC (mg/mL) | |
|---|---|---|---|
| Th-NCs/Or-NCs | Th-NCs/Or-NCs | ||
| P. vancouverensis | 0.5 | 0.25 | 0.125 |
| Flavobacterium sp. | 0.5 | 0.25 | 0.125 |
| P. eringii | 0.125 * | 0.06 | 0.03 |
| P. lilacinum | 0.125 * | 0.06 | 0.03 |
| Strain | Sub-MIC/Biofilm Growth Inhibition Efficiency (%) | |||
|---|---|---|---|---|
| Th-NCs | Or-NCs | |||
| P. vancouverensis | 0.25 (67.4%) | 0.125 (37.8%) | 0.25 (65%) | 0.125 (35.5%) |
| Flavobacterium sp. | 0.25 (61.9%) | 0.125 (29.1%) | 0.25 (64.8%) | 0.125 (31.6%) |
| P. eringii | 0.06 (63.7%) | 0.03 (19.8%) | 0.06 (61.75%) | 0.03 (12.63%) |
| P. lilacinum | 0.06 (63.7%) | 0.03 (19.8%) | 0.06 (61.7%) | 0.03 (12.7%) |
| P. vancouverensis | Flavobacterium sp. | P. lilacinum | P. eryngii | |
|---|---|---|---|---|
| Sandstone | Sandstone | Sandstone | Whitewood | |
| Protection | log10 CFU/mL | |||
| NCs | 7.10 | 7.13 | 7.21 | 7.24 |
| Or-NCs | 4.04 | 4.06 | 5.10 | 5.14 |
| Th-NCs | 4.05 | 4.08 | 5.13 | 5.16 |
| P. vancouverensis | Flavobacterium sp. | P. lilacinum | P. eryngii | |
| Disinfection | log10 CFU/mL | |||
| NCs | 6.05 | 6.06 | 6.13 | 6.11 |
| Or-NCs | ND | ND | ND | ND |
| Th-NCs | ND | ND | ND | ND |
| Protection | P. vancouverensis | Flavobacterium sp. | P. lilacinum | P. eryngii |
|---|---|---|---|---|
| Sandstone | Sandstone | Sandstone | Whitewood | |
| NCs | 793.1 mm2 | 736.0 mm2 | 603.0 mm2 | 287.7 mm2 |
| Or-NCs | 553.6 mm2 | 486.5 mm2 | 535.9 mm2 | 416.0 mm2 |
| Th-NCs | 618.1 mm2 | 449.4 mm2 | 619.3 mm2 | 244.4 mm2 |
| Disinfection | P. vancouverensis | Flavobacterium sp. | P. lilacinum | P. eryngii |
| NCs | 675.2 mm2 | 681.5 mm2 | 542.3 mm2 | 192.2 mm2 |
| Or-NCs | 0 mm2 | 0 mm2 | 0 mm2 | 0 mm2 |
| Th-NCs | 0 mm2 | 0 mm2 | 0 mm2 | 0 mm2 |
| Z -Average Diameter (nm) | PDI | ζ (mV) | EE% | LC% | |
|---|---|---|---|---|---|
| NCs | 185 ± 1 | 0.10 ± 0.03 | −13 ± 1 | - | - |
| Th-NCs | 198 ± 3 | 0.09 ± 0.02 | −11 ± 1 | 84 ± 6 | 52 ± 3 |
| Or-NCs | 200 ± 3 | 0.05 ± 0.03 | −10 ± 2 | 80 ± 9 | 51 ± 4 |
| RI lit a | RI exp b | Class/Compound c | O. vulgare % d | T. capitatus % d |
|---|---|---|---|---|
| Monoterpene hydrocarbons | 27.99 | 22.26 | ||
| 939 | 931 | α-Pinene | 1.37 | 0.79 |
| 991 | 986 | β-Myrcene | 0.66 | 1.29 |
| 1017 | 1013 | α-Terpinene | 0.36 | 1.03 |
| 1025 | 1027 | p-Cymene | 21.54 | 9.26 |
| 1060 | 1058 | γ-Terpinene | 2.16 | 8.22 |
| Oxygenated monoterpenes | 68.66 | 72.88 | ||
| 1097 | 1098 | Linalool | 4.26 | 0.86 |
| 1290 | 1303 | Thymol | 25.02 | 0.58 |
| 1299 | 1319 | Carvacrol | 35.95 | 69.91 |
| Sesquiterpenes | 1.94 | 3.19 | ||
| 1419 | 1425 | β-Caryophyllene | 1.70 | 2.56 |
| Others | 0.47 | 0.22 | ||
| TOTAL | 99.06 | 98.55 |
Disclaimer/Publisher’s Note: The statements, opinions and data contained in all publications are solely those of the individual author(s) and contributor(s) and not of MDPI and/or the editor(s). MDPI and/or the editor(s) disclaim responsibility for any injury to people or property resulting from any ideas, methods, instructions or products referred to in the content. |
© 2023 by the authors. Licensee MDPI, Basel, Switzerland. This article is an open access article distributed under the terms and conditions of the Creative Commons Attribution (CC BY) license (https://creativecommons.org/licenses/by/4.0/).
Share and Cite
Hofbauerová, M.; Rusková, M.; Puškárová, A.; Bučková, M.; Annušová, A.; Majková, E.; Šiffalovič, P.; Granata, G.; Napoli, E.; Geraci, C.; et al. Protection and Disinfection Activities of Oregano and Thyme Essential Oils Encapsulated in Poly(ε-caprolactone) Nanocapsules. Molecules 2023, 28, 1018. https://doi.org/10.3390/molecules28031018
Hofbauerová M, Rusková M, Puškárová A, Bučková M, Annušová A, Majková E, Šiffalovič P, Granata G, Napoli E, Geraci C, et al. Protection and Disinfection Activities of Oregano and Thyme Essential Oils Encapsulated in Poly(ε-caprolactone) Nanocapsules. Molecules. 2023; 28(3):1018. https://doi.org/10.3390/molecules28031018
Chicago/Turabian StyleHofbauerová, Monika, Magdaléna Rusková, Andrea Puškárová, Mária Bučková, Adriana Annušová, Eva Majková, Peter Šiffalovič, Giuseppe Granata, Edoardo Napoli, Corrada Geraci, and et al. 2023. "Protection and Disinfection Activities of Oregano and Thyme Essential Oils Encapsulated in Poly(ε-caprolactone) Nanocapsules" Molecules 28, no. 3: 1018. https://doi.org/10.3390/molecules28031018
APA StyleHofbauerová, M., Rusková, M., Puškárová, A., Bučková, M., Annušová, A., Majková, E., Šiffalovič, P., Granata, G., Napoli, E., Geraci, C., & Pangallo, D. (2023). Protection and Disinfection Activities of Oregano and Thyme Essential Oils Encapsulated in Poly(ε-caprolactone) Nanocapsules. Molecules, 28(3), 1018. https://doi.org/10.3390/molecules28031018

